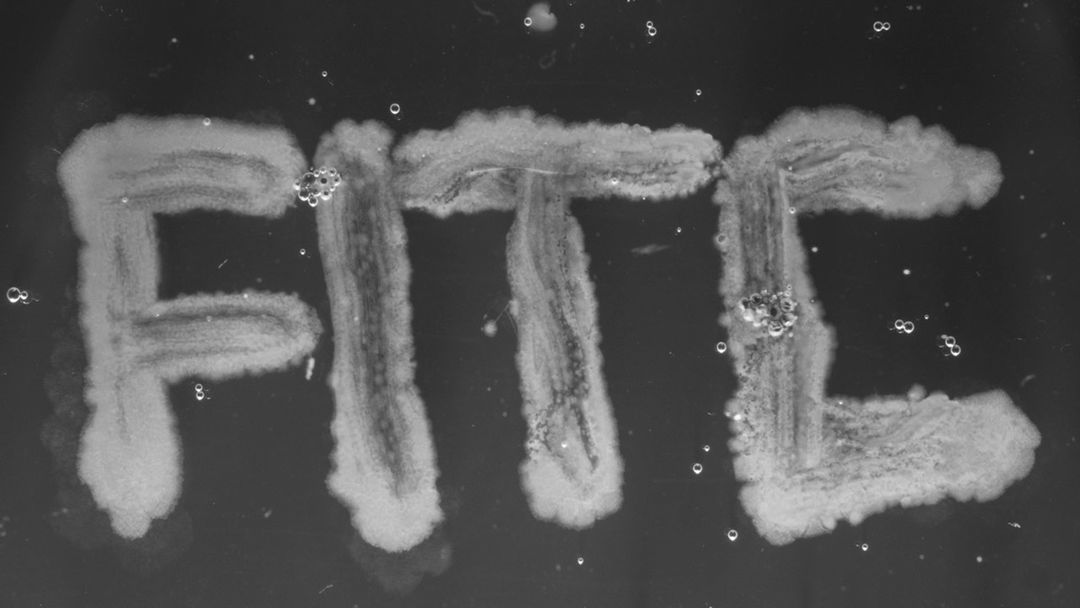

“Human evolution, at first, seems extraordinary. How could the process that gave rise to slugs and oak trees and fish produce a creature that can fly to the moon and invent the Internet and cross the ocean in boats?” —Steven Pinker
Out from the most ancient and basic of substances emerges the opening title sequence to FITC Toronto 2015, a three-day conference celebrating design, web development, media, and innovation in creative technologies.
In this opening by Designer Will Reid and Animation Director Jim Manduca, we are given a sleek vision of evolution, the lines blurred between practical and digital. As we move from the microscopic to the massive, it becomes clear that there’s a connection to be made, lurking beneath these slick gestures. That O, stretching beyond itself and into another, is absolutely smooth – a subtle nod to binary fission. The music, composed by Rob Plowman, is a call of animation and industry and hope. Connection and osmosis and replication. An organism being created to an organism creating.
Conferences like FITC are meant to be agents of change, monoliths that push creatives beyond their limits – instigators of cultural evolution. To enter that arena, we must be open to change. And we must use disorder, communion, and the unexpected to grow stronger and to evolve.
A discussion with Designer WILL REID and Animation Director JIM MANDUCA.
Give us a little background on yourself and what you do.
Will: I’m a motion graphics designer and video editor at Fuel Youth. I graduated from the graphic design program at Algonquin College in Ottawa about 10 years ago. After graduating, I changed my focus and pursued a career in photography that later transitioned into video and motion. I feel like I’ve done a full circle but I’ve collected a lot of useful tools and skill sets along the way.
Jim: I’m the video and 3D animation director at Fuel Youth. I run a small team of people who are way more talented than I am. I started in film in the early ’90s, got into 3D around 2004, and somehow managed to pick up a BSc in biology and psychology along the way.
How did you become involved in this project?
Will: I’ve actually done the highlight reel for FITC Toronto for the past seven years — and once for FITC San Francisco.
FITC Toronto 2013 highlight reel by Fuel Youth
For the most part, a conference highlight reel is pretty straightforward: capture the event and edit it to show potential attendees how much fun it is. After you’ve done a few though, you really want to do something new with it so I started to incorporate mini title sequences into the highlight reels. The idea turned out to be a big hit with FITC and it got to the point where they were excited to see what I’d come up with each year. I was always pretty pumped to work on the one project of the year that offers so much creative freedom and attendance to a pretty kick-ass conference.
This year, FITC founder Shawn Pucknell contacted me with the opportunity to not only tackle the opening titles but the actual creative for the entire conference. It was a huge honour.
Jim: Will and I worked together at Fuel and it just seemed to make sense to work together on this as I dabbled in photomicrography.
What kind of brief did you get from FITC? Did they have a direction in mind?
Will: The brief was pretty limited. Due to the nature of the conference, Shawn was open to ideas. We chatted on the phone a couple of times to kick things off. At that point the theme for that year hadn’t even been established for the conference. Having just watched the Cosmos series with Neil deGrasse Tyson, I pitched the idea of evolution – not just the standard idea of human evolution, but the evolution of technology. The idea stuck, and the theme for the conference was born.
So, based on that idea, where did you start? Where do you start with evolution?
Will: The first stage was to get the conference creative and visuals locked in. The visuals for the conference set the mood for the direction of the titles. First we designed the poster. I worked with my good friend Kyle Skinner on some designs and we submitted a few options, one of which paid homage to Terence McKenna’s Stoned Ape theory.
Image Set: Unused and final FITC Toronto 2015 posters designed by Will Reid and Kyle Skinner.
Although they didn’t go with that option, I still managed to briefly incorporate the idea into the final titles. Once the remainder of the conference artwork was finalized, I was free to focus on the titles. I had a few patio brainstorm sessions with Kyle and generated a huge list or timeline of visuals that could work with the evolution theme. From there it was really just a matter of getting those visuals from paper to the screen one at a time.
Jim: For me it was research. Studying all the microscopy techniques out there, the hardware requirements to achieve those techniques, even making homemade rigs all took incredible amounts of time. At one point I was 3D printing mounts for my iPhone.
Image Set: 3D printed mounts and microscope rig
Tell us about the footage. Was there a live-action shoot for some of the elements in the sequence? How much of it was stock footage?
Will: I really wanted to avoid stock footage as much as possible. Considering the amount of shots, I knew it would be tough. The only instance that I had to bite the bullet and source some stock footage was the ape and the mushroom time-lapse. It’s just not that easy to find an ape in Ottawa in the middle of winter! I had planned to actually film a mushroom time-lapse sequence, but scheduling didn’t work out with the amount of time needed, and all of my camera bodies already in use for other shots. There’s also the one archival shot of the Apollo Lunar Module, but I doubt that shot would have worked as well without sourcing the original footage.

Ape stock footage used in the sequence
Jim: The microscopic footage was shot over three months. We were really trying to use as little stock footage as possible — I almost drove down to Florida to shoot a rocket launch at Cape Canaveral but it didn’t work out. Good thing as the shot Will put together was stunning.
Are those all real bacteria, insects, and animals? Or were they visual effects?
Will: There really isn’t a lot of VFX in this piece. There is something so rewarding about going out, collecting specimens, props, and real materials to bring your vision together.Other than some graphical accents and treatments throughout, the only real VFX shot that was built from the ground up was the rocket launch.
The main title typography was animated in a more analogue fashion. Each word was printed out and then scanned in again, over and over. Each time the type was scanned I shifted the paper in different ways giving me an image sequence of distorted type.
Image Set: Scanned typography examples
Jim: The raw microscopy footage in this piece was the result of at least 300 hours of observations. When something interesting was found or unfolding, it wasn’t always possible to achieve a well-composed frame. There were some spectacular moments witnessed with a dead battery in hand as well!
The sequence climaxes with a series of shots of a face. How did you make that? And whose face is it?
Will: The face at the end was a physical prop. It was achieved by submerging a styrofoam head into a few gallons of white paint and slowly letting it float up to reveal itself. I also ran some medical tubing behind the head through the eye attached to a syringe full of black ink. That’s how I got the eye to pop and ooze the black liquid.
The face doesn’t actually represent anyone, but the whole sequence represents the whole form over function trend that plagues modern technology. Don’t get me wrong, I love technology, and I love design, but I find we’re way more concerned with making things marketable than actually focusing on ironing out ideas and making the technology we already have fully functional.
Image Set: Behind the scenes of the "head" live-action shoot
What about the typography? Tell us about that.
Will: The typeface I used is Hallo Sans by Fredrik Staurland. It’s a really clean and legible sans serif. It compliments the theme and visuals because it has such a nice mix and balance of old and new characteristics.
There’s a famous Hollywood adage that says “Never work with kids or animals.” You do both in this sequence. How did you manage that?
Will: Yeah, kids and animals can be a complete nightmare to work with. I’ve got a lot of first-hand experience with that – most photographers get suckered into the occasional pet or child shoot from time to time – so I was a little prepared although this was a little different. The baby was actually my daughter. She was about six months old when I shot the footage. I really wanted to capture that crying baby shot, which I figured would be an easy one to get. So I kept her up past her bedtime assuming she’d be a little cranky – wasn’t that easy! As soon as I put her under the lights she was all smiles. The exact opposite of what I needed. Patience is key in these situations. If you’re gonna work with kids and animals, you gotta get used to the fact that the talent is in charge.
Image Set: Filming animal skeletons and baby
Jim: Believe it or not, I may be one of the few people that can honestly say they’ve directed a protozoan. I had a great frame of a vorticella as it was fishing itself out into the world via its long stalk. It moved in these beautiful sweeping motions but there was some debris in the sample that it would bump along during its path that I felt was ruining the shot. I learned that by tapping the stage I could cause the little guy to retract before or after hitting this debris. With practice, the vorticella and I got into a pretty good groove where we were taking enter and exit frame shots with some well-timed rack focuses. I’ll have to remember to update my resume.
And so what kind of feedback were you getting from FITC?
Will: They were a dream client. As I mentioned, I'd already developed a relationship with them over the years and it was solid enough that they trusted me to stay pretty hands off throughout. I think I only actually showed them one preliminary cut. Shawn Pucknell didn’t even want to see it beforehand, and only saw the final on the first day of the conference along with everyone else.
Talk about the music for the sequence. Who composed it?
Will: Jim and I had a lot of discussions about the music, and I had a general idea of what I wanted. But at the end of the day our good friend and co-worker Rob Plowman ran with it and knocked it out of the park. I really wanted him to make it his own. I shared a few cuts as production moved on, and he knew what I was editing to for tempo. Other than that he really cut loose and had some fun with it.
Who else did you work with on this? How big was the production team?
Will: There really wasn’t a lot of people involved with this one. Jim was huge help. It was great to have someone that had a knowledge of micro-organisms and biology and knew exactly what I was looking for visually. I knew he’d be able to get me what I needed and he delivered in spades. Kyle Skinner elped get the ball rolling with initial concept and design and he was a good eye to bounce stuff off of during production. Again, Rob Plowman did a fantastic job with the music. And a big thanks to Andrei Anghelescu. Andrei put in some work on a very 3D VFX-heavy shot that didn’t actually make the final cut. It was a gorgeous shot, but keeping with the overall minimal VFX theme of the titles, it just didn’t fit. I still owe him a lunch and a pitcher or two for that.
Will Reid and Jim Manduca out hunting for microscope specimens
Now, technical question. Which tools and software did you use to put it all together?
Will: All of the footage was shot on a Canon 5D MKIII and MKII. I used the Atomos Ninja II to capture the footage. Any DSLR shooters out there that aren’t using an external capture device like the Ninja, I highly recommend you take the time to try it out. There are actually a few shots of bacteria cultures growing at an accelerated pace near the beginning of the titles. Those were time-lapse captures using a macro lens and an infrared-converted Canon 30D. There were lots of different lenses and extension tubes used throughout filming and even some CRT monitors for some effects and transitions. The entire sequence was then edited using Adobe Premiere. Once everything was in place each shot was sent to After Effects for type, colour, or effects. I used the Dynamic Link function that lets Premiere and After Effects speak to each other so I can just round trip back and forth between effects and main timeline. When it works, it's a fantastic workflow, but as soon as it stops working it can be a real pain in the ass, although it seems to be getting a bit more stable with every new release.
Jim: I used an old bright field microscope and a dissecting scope purchased from the university where I attended. I also recently acquired a frankensteined phase contrast scope I put together from parts at a local dealer’s and used that for most of the footage in this piece. I also experimented with external lights sources, glass spheres, filters, polarizers, and played with obstructing the light path with just about anything I could get my hands on.
Typography created by shaping individual bacterium
Was there anything that took you by surprise when working on this sequence?
Will: My biggest surprise actually came after the titles were a wrap. The production was such an adventure, I learned a lot, had fun, lost sleep, and thankfully I ended up with a product I’m proud of. But I really think there was a whole story to this process that will eventually fade away. I really wish I’d documented more of what was going into the project. Just a quick pic here and there and some sketches saved from the garbage can. I’ve received a surprising amount of emails from people inquiring about different aspects and processes to the sequence. Just goes to show, you never know what people will be interested in, so document your projects no matter how big or small.
Jim: I watched species explode and dwindle in mere days as vast populations of organisms competed for resources in this tiny universe. I was mixing samples together and it was surprising how often I found myself on these deep cerebral journeys in the silence of the early morning hours after peering into my scopes all night — it was a welcomed deviation from the agency world I spend my days in. I am a huge advocate of the Multiverse hypothesis, and what infinite and infinitesimal really mean. If you check out the FITC highlights follow up piece we did, I think the last shot really captures what I’m trying to say here.
FITC Toronto 2015 highlight reel created by Fuel Youth.
What are some of your personal favorite title sequences, either classic or contemporary?
Will: I know it’s probably a little predictable or cliché at this point, but the opening titles for Se7en are still my favourite. Those titles really played a big part in my life as far as design and film are concerned. I was fairly young when I saw them for the first time, but it was definitely one of those “I know what I want to do when I grow up” moments. It’s not just the titles, but also the story behind the production of the titles that really excites me. I think that’s where my appreciation for the tactile hands on approach comes from.
Jim: Oddly enough, the titles and intro from the 1991 film Final Approach still seem to wander into my thoughts from time to time. Visually it was okay for the time, but there was this haunting whisper accompanying a flash of light that struck home with me. The film has all the early ’90s cheese you could want but that audio sample still enters my thoughts 20 years later.
Final Approach (1991) title sequence by Filmquest Visual Effects Group
What are some of the things that excite you both outside of the design world?
Will: I’m fairly new to fatherhood with my daughter still being under a year old. I find her incredibly fascinating. It’s a real trip to watch someone start from scratch and how they interact with the world. It actually really helps you step back a bit and look at things differently and with a fresh outlook. Also, riding motorcycles is pretty awesome.
Jim: We are living in an age where absurdly overwhelming discoveries, concepts, and technologies are being announced daily. We hardly notice the scale of the leaps we are making in science and technology due to the sheer volume and frequency of it all. Highly intellectual concepts are becoming “watercooler chat” as more and more media artists accentuate, and in some cases, contribute to this giant body of work through gorgeous design, motion graphics, and video. I sat with my four- and five-year-old sons the other day and watched GoPro footage an astronaut took during a spacewalk. Simply living in this era is exciting and it’s obvious it’s just getting started.
SUPPORT COMES FROM
CINEMA 4D BY MAXON
Featuring an Unmatched Live 3D Pipeline with Adobe After Effects CC








